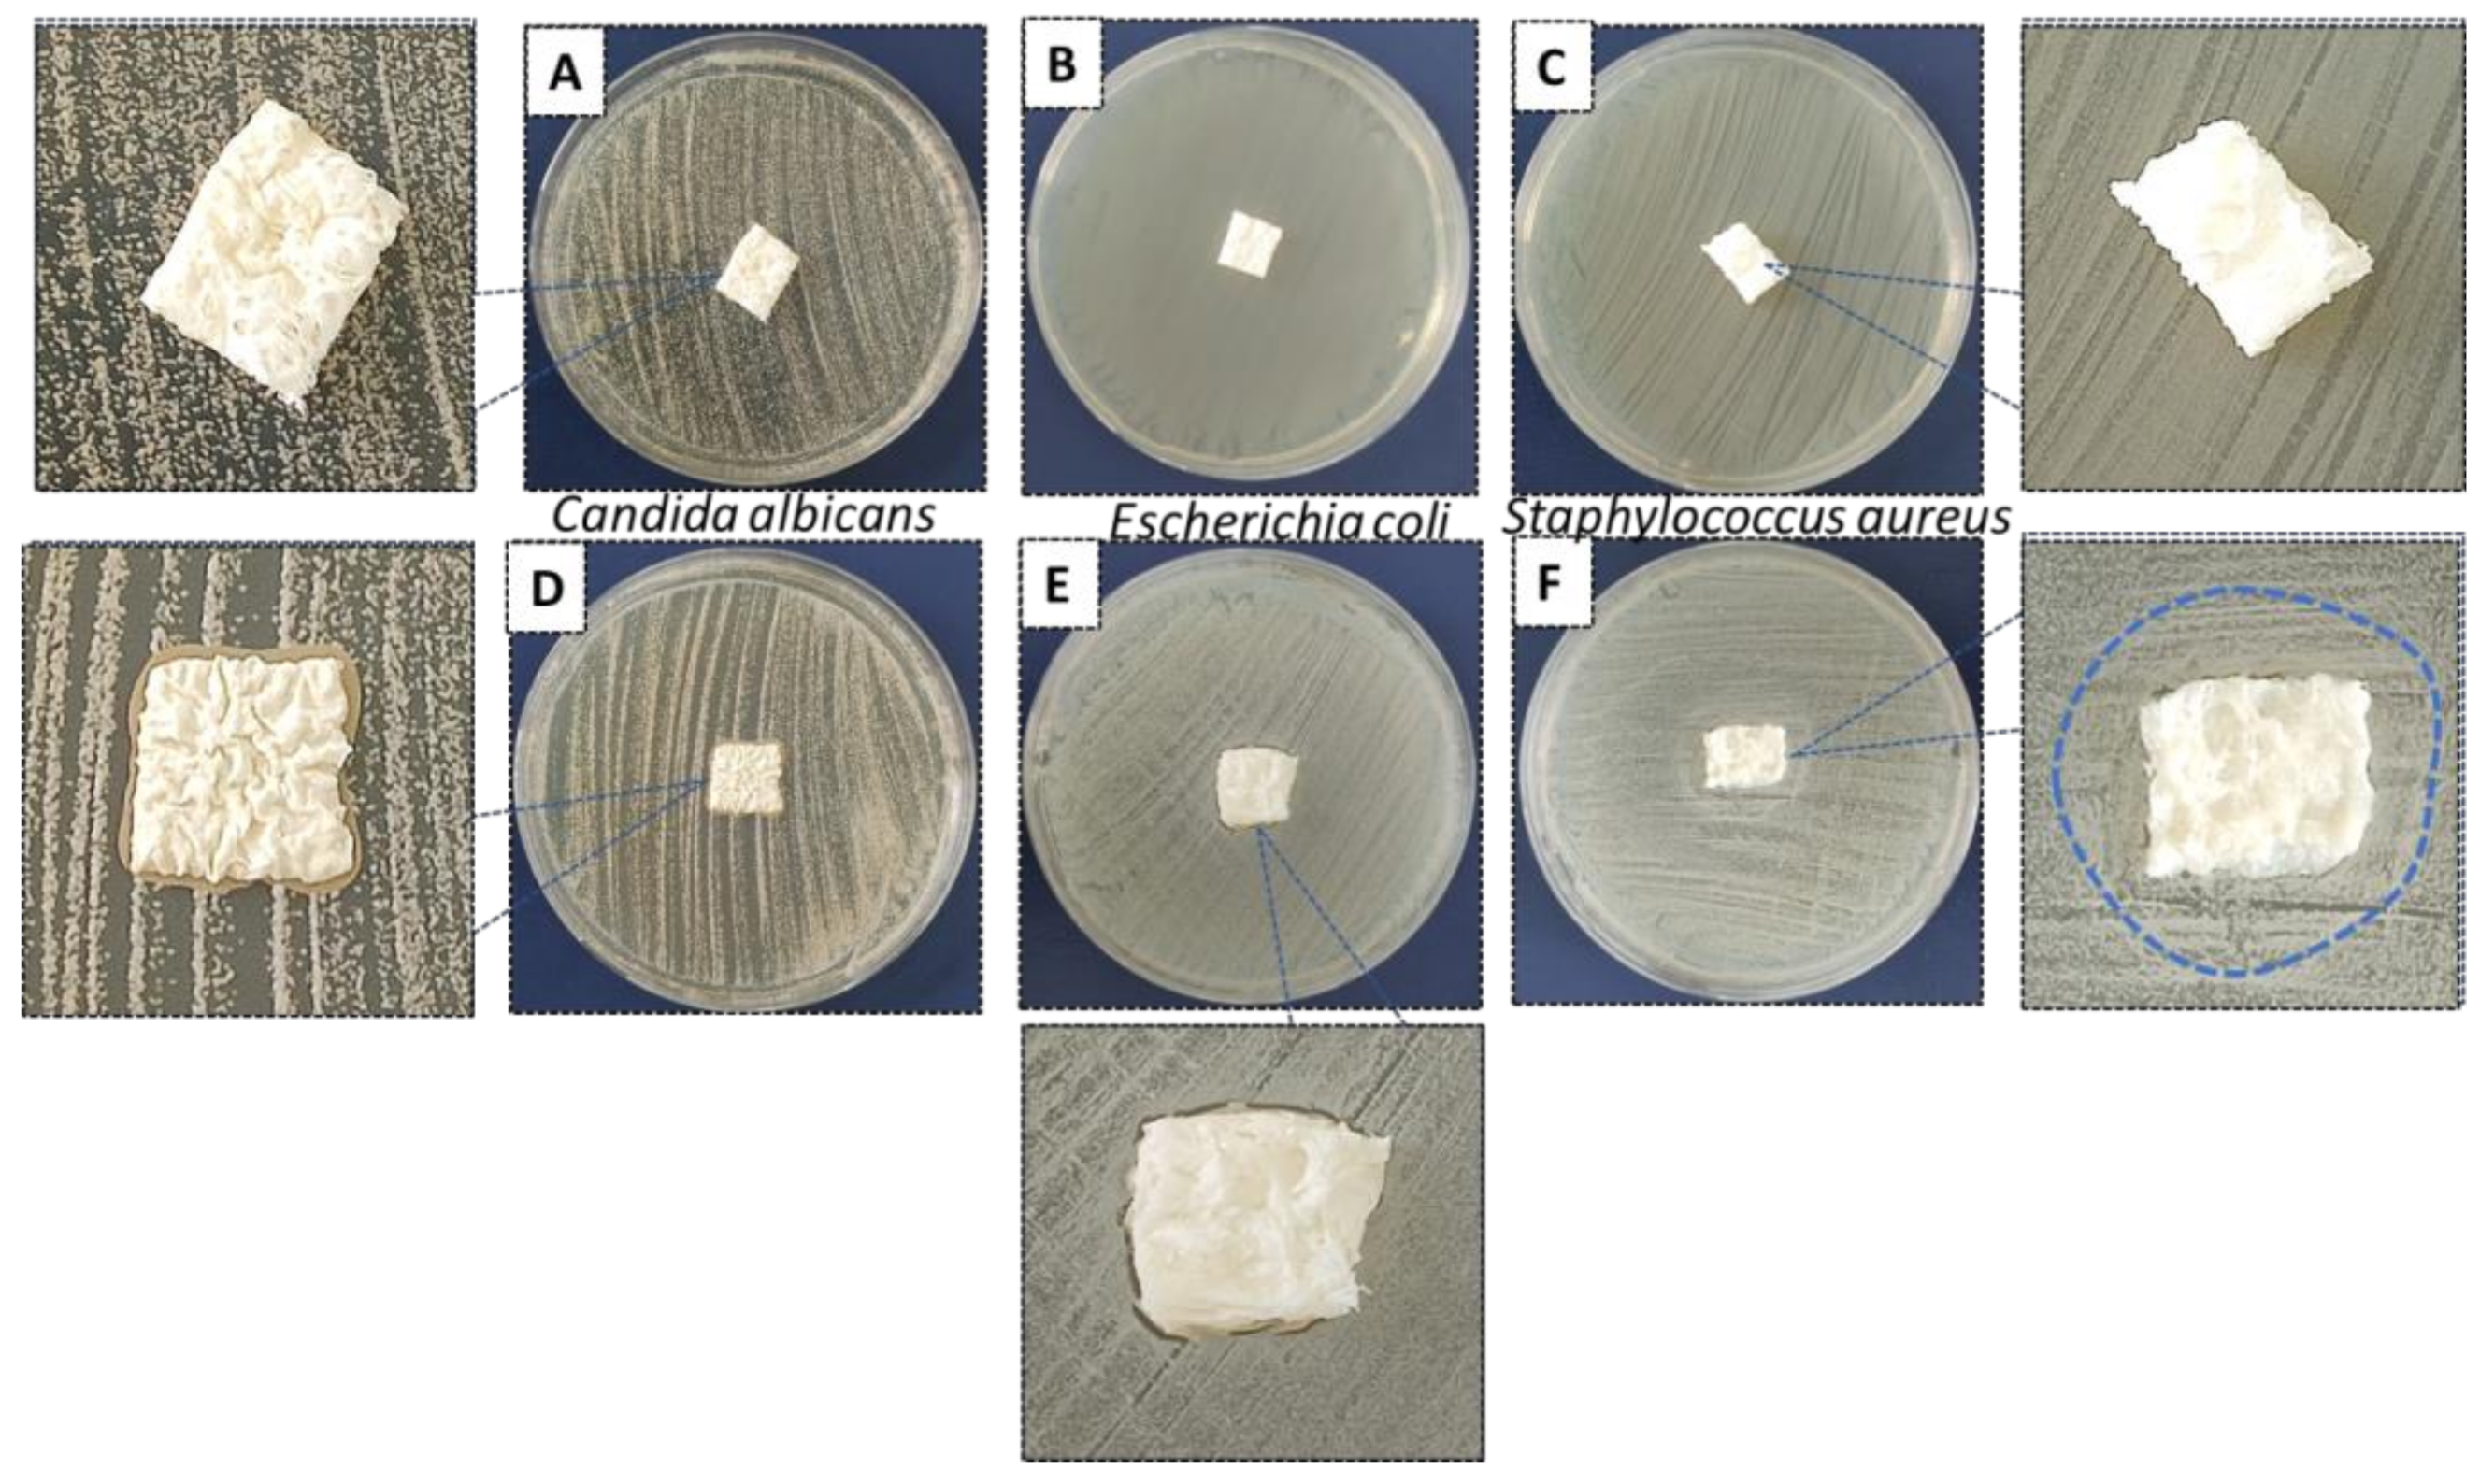
Polymers 15 02446 g015

Piezoelectric Biocomposites for Bone Grafting in Dentistry
Abstract
1. Introduction
2. Materials and Methods
2.1. Biocomposite Synthesis
2.1.1. Hydroxyapatite Nano-Powder (HA)
2.1.2. Potassium–Sodium Niobate Powder (KNN)
2.1.3. Chitosan Solution
2.1.4. Composite Hydrogels and Porous Scaffolds Preparation
2.2. Biocomposite Characterization
2.2.1. X-ray Diffraction
2.2.2. IR-Spectra
2.2.3. Scanning Electron Microscopy (SEM)
2.2.4. BET (Brunauer, Emmett, Teller) Specific Surface Area
2.2.5. Swelling Test and Degradation in SBF
2.2.6. Cell Viability (MTT Assay)
2.2.7. Antibacterial and Antifungal Activity
3. Results and Discussion
3.1. Compositional Characterization
3.1.1. XRD
3.1.2. FTIR
3.2. Morpho-Structural Characterization
3.2.1. SEM Micrography
3.2.2. BET Specific Surface Area
3.3. Swelling Test in SBF
3.4. Degradation of HA-KNN-CSL Series Sponges in SBF
3.5. In Vitro Biocompatibility of 10HA-90KNN-CSL and 90HA-10KNN-CSL Scaffolds and Hydrogels
3.6. Antibacterial and Antifungal Activity of 10HA-90KNN-CSL and 90HA-10KNN-CSL Hydrogels and Scaffolds
4. Conclusions
Supplementary Materials
Author Contributions
Funding
Institutional Review Board Statement
Data Availability Statement
Acknowledgments
Conflicts of Interest
References
- Iviglia, G.; Kargozar, S.; Baino, F. Biomaterials, Current Strategies, and Novel Nano-Technological Approaches for Periodontal Regeneration. J. Funct. Biomater. 2019, 10, 3. [Google Scholar] [CrossRef] [PubMed]
- Greco, F.; Mattoli, V. Introduction to Active Smart Materials for Biomedical Applications; Springer: Berlin/Heidelberg, Germany, 2011. [Google Scholar]
- Haugen, H.J.; Lyngstadaas, S.P.; Rossi, F.; Perale, G. Bone grafts: Which is the ideal biomaterial? J. Clin. Periodontol. 2019, 46 (Suppl. S21), 92–102. [Google Scholar] [CrossRef] [PubMed]
- Amaroli, A.; Ravera, S.; Zekiy, A.; Benedicenti, S.; Pasquale, C. A Narrative Review on Oral and Periodontal Bacteria Microbiota Photobiomodulation, through Visible and Near-Infrared Light: From the Origins to Modern Therapies. Int. J. Mol. Sci. 2022, 23, 1372. [Google Scholar] [CrossRef] [PubMed]
- Yamada, M.; Egusa, H. Current bone substitutes for implant dentistry. J. Prosthodont. Res. 2018, 62, 152–161. [Google Scholar] [CrossRef]
- Sohn, H.S.; Oh, J.K. Review of bone graft and bone substitutes with an emphasis on fracture surgeries. Biomater. Res. 2019, 23, 9. [Google Scholar] [CrossRef]
- Przekora, A. Current Trends in Fabrication of Biomaterials for Bone and Cartilage Regeneration: Materials Modifications and Biophysical Stimulations. Int. J. Mol. Sci. 2019, 20, 435. [Google Scholar] [CrossRef]
- Nitti, P.; Kunjalukkal Padmanabhan, S.; Cortazzi, S.; Stanca, E.; Siculella, L.; Licciulli, A.; Demitri, C. Enhancing Bioactivity of Hydroxyapatite Scaffolds Using Fibrous Type I Collagen. Front. Bioeng. Biotechnol. 2021, 9, 631177. [Google Scholar] [CrossRef]
- Kamel, N.A. Bio-piezoelectricity: Fundamentals and applications in tissue engineering and regenerative medicine. Biophys. Rev. 2022, 14, 717–733. [Google Scholar] [CrossRef]
- Xu, Q.; Gao, X.; Zhao, S.; Liu, Y.N.; Zhang, D.; Zhou, K.; Khanbareh, H.; Chen, W.; Zhang, Y.; Bowen, C. Construction of Bio-Piezoelectric Platforms: From Structures and Synthesis to Applications. Adv. Mater. 2021, 33, e2008452. [Google Scholar] [CrossRef]
- Singh, A.; Dubey, A.K. Various Biomaterials and Techniques for Improving Antibacterial Response. ACS Appl. Bio Mater. 2018, 1, 3–20. [Google Scholar] [CrossRef]
- Li, Y.; Sun, L.; Webster, T.J. The Investigation of ZnO/Poly(vinylidene fluoride) Nanocomposites with Improved Mechanical, Piezoelectric, and Antimicrobial Properties for Orthopedic Applications. J. Biomed. Nanotechnol. 2018, 14, 536–545. [Google Scholar] [CrossRef]
- Neacsu, I.A.; Serban, A.P.; Nicoara, A.I.; Trusca, R.; Ene, V.L.; Iordache, F. Biomimetic Composite Scaffold Based on Naturally Derived Biomaterials. Polymers 2020, 12, 1161. [Google Scholar] [CrossRef]
- Kaliannagounder, V.K.; Raj, N.P.M.J.; Unnithan, A.R.; Park, J.; Park, S.S.; Kim, S.-J.; Park, C.H.; Kim, C.S.; Sasikala, A.R.K. Remotely controlled self-powering electrical stimulators for osteogenic differentiation using bone inspired bioactive piezoelectric whitlockite nanoparticles. Nano Energy 2021, 85, 105901. [Google Scholar] [CrossRef]
- Khare, D.; Singh, A.; Dubey, A.K. Influence of Na and K contents on the antibacterial response of piezoelectric biocompatible NaxK1-xNbO3 (x = 0.2–0.8). Mater. Today Commun. 2021, 27, 102317. [Google Scholar] [CrossRef]
- Ariani, M.D.; Matsuura, A.; Hirata, I.; Kubo, T.; Kato, K.; Akagawa, Y. New development of carbonate apatite-chitosan scaffold based on lyophilization technique for bone tissue engineering. Dent. Mater. J. 2013, 32, 317–325. [Google Scholar] [CrossRef]
- Mima, S.; Miya, M.; Iwamoto, R.; Yoshikawa, S. Highly Deacetylated Chitosan and its Properties. J. Appl. Polym. Sci. 1983, 28, 1909–1917. [Google Scholar] [CrossRef]
- Ioelovich, M. Crystallinity and Hydrophility of Chitin and Chitosan. J. Chem. 2014, 3, 7–14. [Google Scholar]
- de Alvarenga, E.S.; Pereira de Oliveira, C.; Roberto Bellato, C. An approach to understanding the deacetylation degree of chitosan. Carbohydr. Polym. 2010, 80, 1155–1160. [Google Scholar] [CrossRef]
- Amaral, I.F.; Cordeiro, A.L.; Sampaio, P.; Barbosa, M.A. Attachment, spreading and short-term proliferation of human osteoblastic cells cultured on chitosan films with different degrees of acetylation. J. Biomater. Sci. Polym. Ed. 2007, 18, 469–485. [Google Scholar] [CrossRef]
- Wang, J.; de Boer, J.; de Groot, K. Proliferation and differentiation of MC3T3-E1 cells on calcium phosphate/chitosan coatings. J. Dent. Res. 2008, 87, 650–654. [Google Scholar] [CrossRef]
- Saidin, S.; Jumat, M.A.; Mohd Amin, N.A.A.; Saleh Al-Hammadi, A.S. Organic and inorganic antibacterial approaches in combating bacterial infection for biomedical application. Mater. Sci. Eng. C Mater. Biol. Appl. 2021, 118, 111382. [Google Scholar] [CrossRef] [PubMed]
- Ylitalo, R.; Lehtinen, S.; Wuolijoki, E.; Ylitalo, P.; Lehtimäki, T. Cholesterol-lowering Properties and Safety of Chitosan. Arzneim.-Forsch./Drug Res. 2002, 52, 1–7. [Google Scholar] [CrossRef] [PubMed]
- Radwan-Praglowska, J.; Piatkowski, M.; Deineka, V.; Janus, L.; Korniienko, V.; Husak, E.; Holubnycha, V.; Liubchak, I.; Zhurba, V.; Sierakowska, A.; et al. Chitosan-Based Bioactive Hemostatic Agents with Antibacterial Properties-Synthesis and Characterization. Molecules 2019, 24, 2629. [Google Scholar] [CrossRef] [PubMed]
- Li, H.; Zhou, C.-R.; Zhu, M.-Y.; Tian, J.-H.; Rong, J.-H. Preparation and Characterization of Homogeneous Hydroxyapatite/Chitosan Composite Scaffolds via In-Situ Hydration. J. Biomater. Nanobiotechnol. 2010, 1, 42–49. [Google Scholar] [CrossRef]
- Said, H.A.; Noukrati, H.; Ben Youcef, H.; Bayoussef, A.; Oudadesse, H.; Barroug, A. Mechanical Behavior of Hydroxyapatite-Chitosan Composite: Effect of Processing Parameters. Minerals 2021, 11, 213. [Google Scholar] [CrossRef]
- Erdem, U.; Dogan, M.; Metin, A.U.; Baglar, S.; Turkoz, M.B.; Turk, M.; Nezir, S. Hydroxyapatite-based nanoparticles as a coating material for the dentine surface: An antibacterial and toxicological effect. Ceram. Int. 2020, 46, 270–280. [Google Scholar] [CrossRef]
- Dewi, A.H.; Ana, I.D. The use of hydroxyapatite bone substitute grafting for alveolar ridge preservation, sinus augmentation, and periodontal bone defect: A systematic review. Heliyon 2018, 4, e00884. [Google Scholar] [CrossRef]
- Mosina, M.; Locs, J. Synthesis of Amorphous Calcium Phosphate: A Review. Key Eng. Mater. 2020, 850, 199–206. [Google Scholar] [CrossRef]
- Moerbeck-Filho, P.; Sartoretto, S.C.; Uzeda, M.J.; Barreto, M.; Medrado, A.; Alves, A.; Calasans-Maia, M.D. Evaluation of the In Vivo Biocompatibility of Amorphous Calcium Phosphate-Containing Metals. J. Funct. Biomater. 2020, 11, 45. [Google Scholar] [CrossRef]
- Cestari, F.; Agostinacchio, F.; Galotta, A.; Chemello, G.; Motta, A.; Sglavo, V.M. Nano-Hydroxyapatite Derived from Biogenic and Bioinspired Calcium Carbonates: Synthesis and In Vitro Bioactivity. Nanomaterials 2021, 11, 264. [Google Scholar] [CrossRef]
- Suresh Kumar, C.; Dhanaraj, K.; Vimalathithan, R.M.; Ilaiyaraja, P.; Suresh, G. Hydroxyapatite for bone related applications derived from sea shell waste by simpleprecipitation method. J. Asian Ceram. Soc. 2020, 8, 416–429. [Google Scholar] [CrossRef]
- Pinto, T.S.; Martins, B.R.; Ferreira, M.R.; Bezerra, F.; Zambuzzi, W.F. Nanohydroxyapatite-Blasted Bioactive Surface Drives Shear-Stressed Endothelial Cell Growth and Angiogenesis. Biomed. Res. Int. 2022, 2022, 1433221. [Google Scholar] [CrossRef]
- Guo, F.; Yuan, C.; Huang, H.; Deng, X.; Bian, Z.; Wang, D.; Dou, K.; Mei, L.; Zhou, Q. Regulation of T Cell Responses by Nano-Hydroxyapatite to Mediate the Osteogenesis. Front. Bioeng. Biotechnol. 2022, 10, 884291. [Google Scholar] [CrossRef]
- Anil, A.; Ibraheem, W.I.; Meshni, A.A.; Preethanath, R.S.; Anil, S. Nano-Hydroxyapatite (nHAp) in the Remineralization of Early Dental Caries: A Scoping Review. Int. J. Environ. Res. Public Health 2022, 19, 5629. [Google Scholar] [CrossRef]
- Tuwalska, A.; Sionkowska, A.; Bryla, A.; Tylko, G.; Osyczka, A.M.; Laus, M.; Vojtova, L. A Biological Study of Composites Based on the Blends of Nanohydroxyapatite, Silk Fibroin and Chitosan. Materials 2022, 15, 5444. [Google Scholar] [CrossRef]
- Mohd Pu’ad, N.A.S.; Alipal, J.; Abdullah, H.Z.; Idris, M.I.; Lee, T.C. Synthesis of eggshell derived hydroxyapatite via chemical precipitation and calcination method. Mater. Today Proc. 2021, 42, 172–177. [Google Scholar] [CrossRef]
- Singh, G.; Singh, R.P.; Jolly, S.S. Customized hydroxyapatites for bone-tissue engineering and drug delivery applications: A review. J. Sol-Gel Sci. Technol. 2020, 94, 505–530. [Google Scholar] [CrossRef]
- Agbeboh, N.I.; Oladele, I.O.; Daramola, O.O.; Adediran, A.A.; Olasukanmi, O.O.; Tanimola, M.O. Environmentally sustainable processes for the synthesis of hydroxyapatite. Heliyon 2020, 6, e03765. [Google Scholar] [CrossRef]
- Jacob, J.; More, N.; Kalia, K.; Kapusetti, G. Piezoelectric smart biomaterials for bone and cartilage tissue engineering. Inflamm. Regen. 2018, 38, 2. [Google Scholar] [CrossRef]
- Janusas, T.; Urbaite, S.; Palevicius, A.; Nasiri, S.; Janusas, G. Biologically Compatible Lead-Free Piezoelectric Composite for Acoustophoresis Based Particle Manipulation Techniques. Sensors 2021, 21, 483. [Google Scholar] [CrossRef]
- Licciardello, M.; Tonda-Turo, C.; Gallina, A.; Ciofani, G.; Ciardelli, G. Fabrication of extracellular matrix-like membranes for loading piezoelectric nanoparticles. J. Phys. Mater. 2020, 3, 034004. [Google Scholar] [CrossRef]
- Kapat, K.; Shubhra, Q.T.H.; Zhou, M.; Leeuwenburgh, S. Piezoelectric Nano-Biomaterials for Biomedicine and Tissue Regeneration. Adv. Funct. Mater. 2020, 30, 1909045. [Google Scholar] [CrossRef]
- Kharisov, B.I.; Kharissova, O.V.; Mendez, U.O. Microwave Hydrothermal and Solvothermal Processing of Materials and Compounds. Dev. Appl. Microw. Heat. 2012, 5, 107–140. [Google Scholar]
- Karunakaran, G.; Kumar, G.S.; Cho, E.-B.; Sunwoo, Y.; Kolesnikov, E.; Kuznetsov, D. Microwave-assisted hydrothermal synthesis of mesoporous carbonated hydroxyapatite with tunable nanoscale characteristics for biomedical applications. Ceram. Int. 2019, 45, 970–977. [Google Scholar] [CrossRef]
- Su, Y.; Wang, J.; Li, S.; Zhu, J.; Liu, W.; Zhang, Z. Self-templated microwave-assisted hydrothermal synthesis of two-dimensional holey hydroxyapatite nanosheets for efficient heavy metal removal. Environ. Sci. Pollut. Res. 2019, 26, 30076–30086. [Google Scholar] [CrossRef] [PubMed]
- Tandon, B.; Blaker, J.J.; Cartmell, S.H. Piezoelectric materials as stimulatory biomedical materials and scaffolds for bone repair. Acta Biomater. 2018, 73, 1–20. [Google Scholar] [CrossRef]
- Zanfir, A.V.; Voicu, G.; Busuioc, C.; Jinga, S.I.; Albu, M.G.; Iordache, F. New Coll-HA/BT composite materials for hard tissue engineering. Mater. Sci. Eng. C Mater. Biol. Appl. 2016, 62, 795–805. [Google Scholar] [CrossRef]
- More, N.; Kapusetti, G. Piezoelectric material—A promising approach for bone and cartilage regeneration. Med. Hypotheses 2017, 108, 10–16. [Google Scholar] [CrossRef]
- Zhao, R.; Yang, R.; Cooper, P.R.; Khurshid, Z.; Shavandi, A.; Ratnayake, J. Bone Grafts and Substitutes in Dentistry: A Review of Current Trends and Developments. Molecules 2021, 26, 3007. [Google Scholar] [CrossRef]
- Tang, Y.; Wu, C.; Wu, Z.; Hu, L.; Zhang, W.; Zhao, K. Fabrication and in vitro biological properties of piezoelectric bioceramics for bone regeneration. Sci. Rep. 2017, 7, 43360. [Google Scholar] [CrossRef]
- Rajabi, A.H.; Jaffe, M.; Arinzeh, T.L. Piezoelectric materials for tissue regeneration: A review. Acta Biomater. 2015, 24, 12–23. [Google Scholar] [CrossRef]
- Yu, S.-W.; Kuo, S.-T.; Tuan, W.-H.; Tsai, Y.-Y.; Wang, S.-F. Cytotoxicity and degradation behavior of potassium sodium niobate piezoelectric ceramics. Ceram. Int. 2012, 38, 2845–2850. [Google Scholar] [CrossRef]
- Yao, T.; Chen, J.; Wang, Z.; Zhai, J.; Li, Y.; Xing, J.; Hu, S.; Tan, G.; Qi, S.; Chang, Y.; et al. The antibacterial effect of potassium-sodium niobate ceramics based on controlling piezoelectric properties. Colloids Surf. B Biointerfaces 2019, 175, 463–468. [Google Scholar] [CrossRef]
- Khare, D.; Basu, B.; Dubey, A.K. Electrical stimulation and piezoelectric biomaterials for bone tissue engineering applications. Biomaterials 2020, 258, 120280. [Google Scholar]
- Dumitrescu, C.R.; Neacsu, I.A.; Surdu, V.A.; Nicoara, A.I.; Iordache, F.; Trusca, R.; Ciocan, L.T.; Ficai, A.; Andronescu, E. Nano-Hydroxyapatite vs. Xenografts: Synthesis, Characterization, and In Vitro Behavior. Nanomaterials 2021, 11, 2289. [Google Scholar] [CrossRef]
- Dumitrescu, C.R.; Surdu, V.A.; Stroescu, H.; Nicoara, A.I.; Neacsu, I.A.; Trusca, R.; Andronescu, E.; Ciocan, L.T. Alkali Niobate Powder Synthesis Using an Emerging Microwave-Assisted Hydrothermal Method. Materials 2022, 15, 5410. [Google Scholar] [CrossRef]
- Wu, S.; Ma, S.; Zhang, C.; Cao, G.; Wu, D.; Gao, C.; Lakshmanan, S. Cryogel biocomposite containing chitosan-gelatin/cerium-zinc doped hydroxyapatite for bone tissue engineering. Saudi J. Biol. Sci. 2020, 27, 2638–2644. [Google Scholar] [CrossRef]
- Kokubo, T.; Kushitani, H.; Sakka, S.; Kitsugi, T.; Yamamuro, T. Solutions able to reproduce in vivo surface-structure changes in bioactive glass-ceramic A-W3. J. Biomed. Mater. Res. 1990, 24, 721–734. [Google Scholar] [CrossRef]
- Lestari, W.; Yusry, W.; Haris, M.S.; Jaswir, I.; Idrus, E. A glimpse on the function of chitosan as a dental hemostatic agent. Jpn. Dent. Sci. Rev. 2020, 56, 147–154. [Google Scholar] [CrossRef]
- da Silva Buriti, J.; Barreto, M.E.V.; Santos, K.O.; Fook, M.V.L. Thermal, morphological, spectroscopic and biological study of chitosan, hydroxyapatite and wollastonite biocomposites. J. Therm. Anal. Calorim. 2018, 134, 1521–1530. [Google Scholar] [CrossRef]
- Kokubo, T.; Takadama, H. How useful is SBF in predicting in vivo bone bioactivity? Biomaterials 2006, 27, 2907–2915. [Google Scholar] [CrossRef] [PubMed]
- Baino, F.; Yamaguchi, S. The Use of Simulated Body Fluid (SBF) for Assessing Materials Bioactivity in the Context of Tissue Engineering: Review and Challenges. Biomimetics 2020, 5, 57. [Google Scholar] [CrossRef] [PubMed]
- Takadama, H.; Hashimoto, M.; Mizuno, M.; Kokubo, T. Round-robin test of SBF for in vitro measurement of apatite-forming ability of synthetic materials. Phosphorous Res. Bull. 2004, 17, 119–125. [Google Scholar] [CrossRef] [PubMed]
- Lee, Y. Association between osteoporosis and periodontal disease among menopausal women: The 2013–2015 Korea National Health and Nutrition Examination Survey. PLoS ONE 2022, 17, e0265631. [Google Scholar] [CrossRef]
- Ferraz, M.P.; Monteiro, F.J.; Manuel, C.M. Hydroxyapatite nanoparticles: A review of preparation methodologies. J. Appl. Biomater. Biomech. 2004, 2, 74–80. [Google Scholar]
- Paci, C.; Iberite, F.; Arrico, L.; Vannozzi, L.; Parlanti, P.; Gemmi, M.; Ricotti, L. Piezoelectric nanocomposite bioink and ultrasound stimulation modulate early skeletal myogenesis. Biomater. Sci. 2022, 10, 5265–5283. [Google Scholar] [CrossRef]
- Verma, A.S.; Singh, A.; Kumar, D.; Dubey, A.K. Electro-mechanical and Polarization-Induced Antibacterial Response of 45S5 Bioglass-Sodium Potassium Niobate Piezoelectric Ceramic Composites. ACS Biomater. Sci. Eng. 2020, 6, 3055–3069. [Google Scholar] [CrossRef]
- Predoi, D.; Ciobanu, C.S.; Iconaru, S.L.; Predoi, S.A.; Chifiriuc, M.C.; Raaen, S.; Badea, M.L.; Rokosz, K. Impact of Gamma Irradiation on the Properties of Magnesium-Doped Hydroxyapatite in Chitosan Matrix. Materials 2022, 15, 5372. [Google Scholar] [CrossRef]

| Sample Name | Hydroxyapatite (HA) (g) | Potassium–Sodium Niobate (KNN) (g) | Chitosan * (CSL) (mL) | Type |
|---|---|---|---|---|
| CSLG | - | - | 30 mL | gel |
| 90HA-10KNN-CSLG | 1.26 | 0.14 | 30 mL | gel |
| 10HA-90KNN-CSLG | 0.14 | 1.26 | 30 mL | gel |
| 50HA-50KNN-CSLG | 0.7 | 0.7 | 30 mL | gel |
| CSL | - | - | 30 mL | scaffold |
| 90HA-10KNN-CSL | 1.26 | 0.14 | 30 mL | scaffold |
| 10HA-90KNN-CSL | 0.14 | 1.26 | 30 mL | scaffold |
| 50HA-50KNN-CSL | 0.7 | 0.7 | 30 mL | scaffold |
| Property | 10HA-90KNN-CSL | 50HA-50KNN-CSL | 90HA-10KNN-CSL |
|---|---|---|---|
| BET specific surface area ± SD (m2/g) | 18.4 ± 0.7 | 21.8 ± 0.4 | 24 ± 1.9 |
| Mean pore diameter—adsorption (4 V/A) ± SD (nm) | 20.8 ± 34.8 | 19.7 ± 33.7 | 19.7 ± 33.5 |
| Mean pore diameter—desorption (4 V/A) ± SD (nm) | 12.5 ± 15.6 | 12 ± 15.3 | 11.7 ± 15 |
| Maximum pore diameter (adsorption nm) | 161.2 | 74.6 | 154.6 |
| Minimum pore diameter (adsorption nm) | 1.8 | 1.6 | 1.7 |
| Identified Element | 10HA-90KNN-CSL | 50HA-50KNN-CSL | 90HA-10KNN-CSL | |||
|---|---|---|---|---|---|---|
| Quantity (at. %/abs. Error %) | ||||||
| Before | After | Before | After | Before | After | |
| C K | 48.4/99.9 | 9.9/99.9 | 47.1/90.9 | 15.2/99.9 | 32.6/99.9 | 11.2/99.9 |
| O K | 14.4/10.6 | 8.5/13.8 | 26.2/21 | 20.5/13 | 41/13.8 | 24.6/10.6 |
| Na K | 1.1/9.3 | 35/8.6 | 1.8/1.3 | 20.8/7.4 | 2/18 | 19.8/9.3 |
| P K | 0.9/7.7 | 3.1/16.2 | 1.6/0.15 | 6.6/18.2 | 7.7/22.6 | 7.7/7.7 |
| Nb L | 18.6/36.2 | 10.2/21.7 | 17.5/22.9 | 4/22.9 | 7.6/21.7 | - |
| Cl K | 13.3/6.6 | 27.5/5.6 | - | 22.2/4.1 | - | 14.4/6.6 |
| K K | 1.7/5.5 | 0.5/22.6 | 3/22.3 | 0.2/29.2 | 1.9/5.1 | 9.5/5.5 |
| Ca K | 1.5/15.7 | 5.2/18.1 | 2.8/7.3 | 10.5/73.3 | 7.1/82.3 | 12.9/22.7 |
| Ca/P | 1.63 | 1.67 | 1.78 | 1.60 | 0.92 | 1.68 |
Disclaimer/Publisher’s Note: The statements, opinions and data contained in all publications are solely those of the individual author(s) and contributor(s) and not of MDPI and/or the editor(s). MDPI and/or the editor(s) disclaim responsibility for any injury to people or property resulting from any ideas, methods, instructions or products referred to in the content. |
© 2023 by the authors. Licensee MDPI, Basel, Switzerland. This article is an open access article distributed under the terms and conditions of the Creative Commons Attribution (CC BY) license (https://creativecommons.org/licenses/by/4.0/).
Share and Cite
Dumitrescu, C.R.; Neacsu, I.A.; Trusca, R.; Popescu, R.C.; Raut, I.; Constantin, M.; Andronescu, E. Piezoelectric Biocomposites for Bone Grafting in Dentistry. Polymers 2023, 15, 2446. https://doi.org/10.3390/polym15112446
Dumitrescu CR, Neacsu IA, Trusca R, Popescu RC, Raut I, Constantin M, Andronescu E. Piezoelectric Biocomposites for Bone Grafting in Dentistry. Polymers. 2023; 15(11):2446. https://doi.org/10.3390/polym15112446
Chicago/Turabian StyleDumitrescu, Cristina Rodica, Ionela Andreea Neacsu, Roxana Trusca, Roxana Cristina Popescu, Iuliana Raut, Mariana Constantin, and Ecaterina Andronescu. 2023. "Piezoelectric Biocomposites for Bone Grafting in Dentistry" Polymers 15, no. 11: 2446. https://doi.org/10.3390/polym15112446
APA StyleDumitrescu, C. R., Neacsu, I. A., Trusca, R., Popescu, R. C., Raut, I., Constantin, M., & Andronescu, E. (2023). Piezoelectric Biocomposites for Bone Grafting in Dentistry. Polymers, 15(11), 2446. https://doi.org/10.3390/polym15112446

